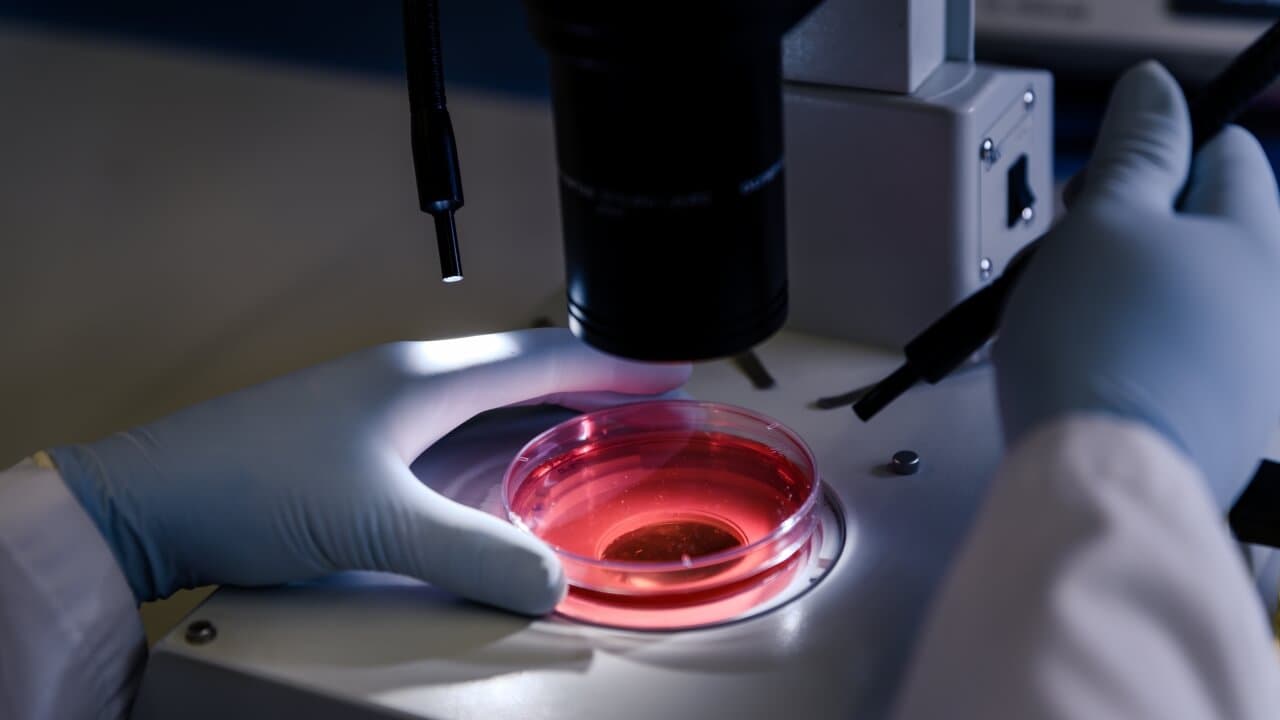
главное фото

04 августа 2023
По их результатам он сможет получить ускоренное одобрение в США.
Биофармацевтическая компания Astria Therapeutics занимается созданием нового препарата STAR-0215 для лечения наследственного ангиоотека. На днях он получил преимущество ускоренного одобрения («fast track designation»). Этот статус присваивает Американское управление по контролю за качеством пищевой продукции и лекарственных препаратов (FDA). Он дает возможность получить одобрение в кратчайшие сроки, так как на рынке еще нет эффективных методов лечения этого заболевания.
Наследственный ангиоотек (НАО) — редкое, опасное заболевание из группы первичных иммунодефицитов. Болезнь проявляется непредсказуемым появлением на теле плотных и холодных отеков. Они могут затрагивать один или несколько участков тела, продолжаться от одного до четырех-пяти дней, вызывая сильную боль и дискомфорт, а также угрожающее жизни удушье.
STAR-0215 — это препарат, подавляющий действие особого фермента плазмы — калликреина. Из-за генетической мутации у людей с НАО повышается уровень калликреина в плазме, что приводит к избыточному образованию белка брадикинина. Именно он становится катализатором болезни и вызывает возникновение отеков.
Препарат STAR-0215 в настоящее время проходит клиническое исследование на людях. Его результаты будут известны в середине 2024 года. Ранее, в декабре 2022 года, Astria Therapeutics объявила о положительных предварительных результатах первой фазы испытаний. Создатели лекарства считают, что в будущем оно может стать препаратом первой очереди выбора для профилактики ангиоотеков, при этом вводить его потребуется не чаще одного раза в три или шесть месяцев.
В настоящее время для профилактики отеков при НАО уже существуют различные препараты, среди них ингибитор С1-эстеразы человека, беротральстат, ланаделумаб, транексамовая кислота и даназол. Однако эти препараты требуют частого введения.
ООО «ЭМГ» г. Москва, ул. Народная, д. 14, стр. 3
ОГРН 5087746488440
© Помощь редким, 2026
Напишите нам
Info@rare-aid.com